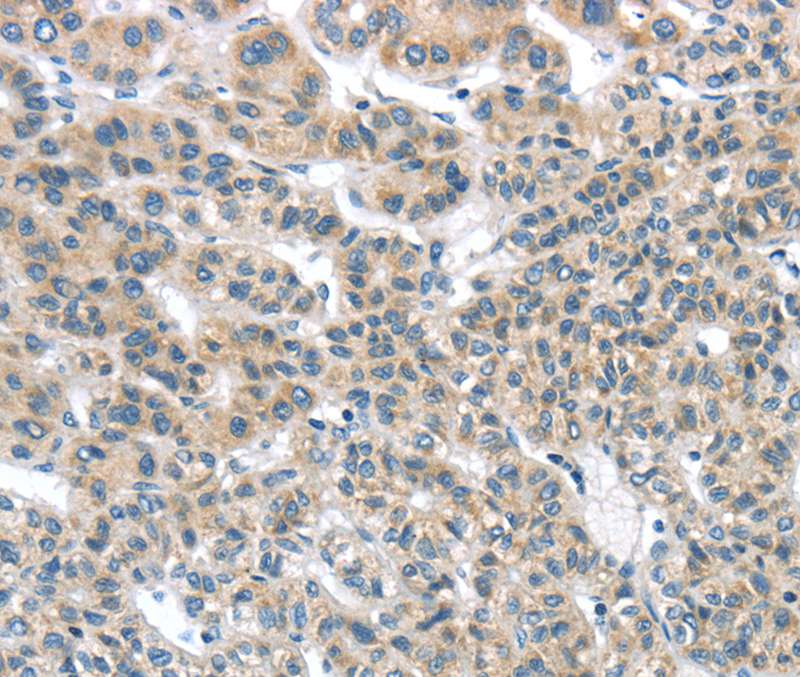

Immunohistochemistry of paraffin-embedded Human liver cancer tissue using TA365068 (THSD1 Antibody) at dilution 1/25 (Original magnification: x200)
THSD1 Rabbit Polyclonal Antibody
TA365068
Overview
- SupplierOriGene
- Product NameTHSD1 Rabbit Polyclonal Antibody
- Delivery Days Customer14
- ApplicationsImmunoHistoChemistry
- CertificationResearch Use Only
- ClonalityPolyclonal
- Gene ID55901
- Target nameTHSD1
- Target descriptionthrombospondin type 1 domain containing 1
- Target synonyms4833423O18Rik; ANIB12; thrombospondin type-1 domain-containing protein 1; thrombospondin, type I, domain containing 1; TMTSP; transmembrane molecule with thrombospondin module; UNQ3010
- HostRabbit
- IsotypeIgG
- Protein IDQ9NS62
- Protein NameThrombospondin type-1 domain-containing protein 1
- Scientific DescriptionTHSD1 rabbit polyclonal antibody
- Storage Instruction-20°C
- UNSPSC12352203